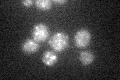
YBR205W
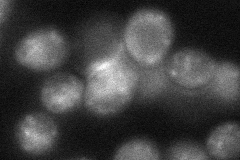
YBR205W
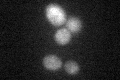
YBR205W
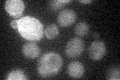
YBR205W
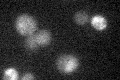
YBR205W

View description
Putative alpha-1,2-mannosyltransferase involved in O- and N-linked protein glycosylation; member of the KRE2/MNT1 mannosyltransferase family
Localization:
Intensity:
Fold change:
Significance:
-
C’ GFP library in SD
vacuole19.9 -
N' NOP1pr-GFP in SD

punctate,vacuole98.928 -
N' TEF2pr-mCherry in SD

vacuole181.367 -
N' NATIVEpr-GFP in SD

punctate27.1021 -
N' TEF2pr-VC and Cyto-VN in SD
punctate38.7201 -
C’ GFP library in SD+DTT
vacuole17.550.88No -
C’ GFP library in SD+H2O2
vacuole19.280.96No -
C’ GFP library in Starvation Media
vacuole18.270.91No -
C’ GFP library on the background of Pup2-DaMP

vacuole -
C’ GFP library on the background of CCT mutant

vacuole18.04810.906592No
